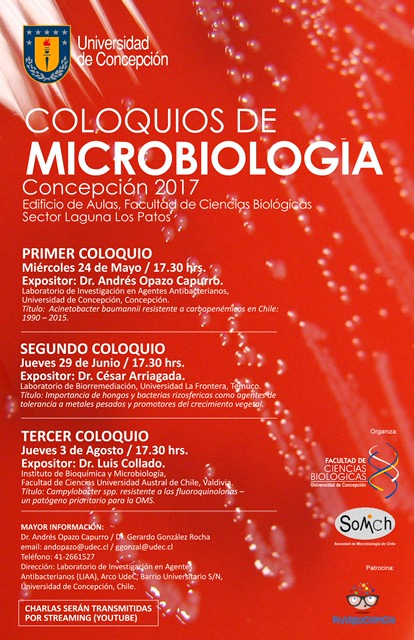
image1

Noticias


NOVIEMBRE 2025: Luis Collado presentó la charla “Resistencia antibiótica en cepas de Campylobacter jejuni aisladas de animales de producción en Chile” en un seminario virtual organizado por la Agencia Chilena para la inocuidad y Calidad alimentaria (ACHIPIA) para abordar los desafíos de la resistencia a los antimicrobianos en la cadena alimentaria https://www.postgradociencias.uach.cl/dr-luis-collado-abordo-la-resistencia-antibiotica-en-campylobacter-jejuni-en-seminario-de-achipia/.



Noviembre 2025. Hemos asistido al XXVII Congreso Latinoamericano de Microbiología ALAM 2025 en Santo Domingo, República Dominicana. El estudio presentado por Tatiana Camacho ha obtenido un reconocimiento como uno de los mejores poster del congreso. Felicitaciones a todos los coautores del estudio y en especial a Tati 👏👏👏.



Diciembre 2024: Mónica Lopez-Cantillo y Tatiana Camacho-Suntaxi han presentado sus investigaciones en el XLVI Congreso Chileno de Microbiología de la SoMiCh en Coquimbo, Chile.


NOVIEMBRE 2023: CampyLab ha participado de los Coloquios de la Sociedad Chilena de Microbiología (SOMICh) con la charla «Taxonomía y epidemiología molecular de bacterias zoonóticas emergentes», en Puerto Montt, Chile.


NOVIEMBRE 2023: Sebastián Cifuentes ha presentado el trabajo «Evaluación del desempeño diagnóstico de medios de cultivo cromogénicos para el aislamiento de Campylobacter spp. en muestras fecales de pacientes con gastroenteritis» en la XXXVIII Congreso Chileno de Infectología, en Coquimbo, Chile.


Agosto 2023. Hemos asistido al XXVI Congreso Latinoamericano de Microbiología ALAM 2023 en Quito, Ecuador. El estudio presentado por Jose L. González ha obtenido el cuarto premio en la categoría Microbiología Clínica. Felicitaciones a todos los coautores del estudio y en especial a Jose. la foto de izda. a dcha: M. Concha-Toloza, S. Ochoa, L. Collado, B. Vidal y J.L. González.
Enero 2023. Comenzando el año hemos recibido la visita del Dr. José Arturo Molina, académico de la Facultad de Microbiología de la U. de Costa Rica. La visita del Dr. Molina se efectuó en el marco de un trabajo colaborativo con nuestro laboratorio en el área del análisis bioinformático de genomas bacterianos como parte del proyecto de investigación FONDECYT Regular 1200125. Más información en Noticias UACh.


Diciembre 2022: Recientemente hemos asistido al XLIV Congreso Chileno de Microbiología de la SoMiCh en La Serena, Chile. En la foto de izda. a dcha: Mónica Lopez-Cantillo, Luis Collado, Mauricio Cockbaine, Jose Luis González y Macarena Concha-Toloza.
Noviembre 2022. Luis Collado presento la charla online titulada “¿Cuál es el origen de la resistencia antibiótica de Campylobacter jejuni en Chile?” en las IV Jornadas de Bioinformática Clínica, Costa Rica.


Octubre 2022. Luis Collado presento la conferencia titulada “Resistencia antimicrobiana en agentes comunitarios prioritarios: Campylobacter spp.” en el XXXVII Congreso Chileno de Infectología en Santiago, Chile

Diciembre 2021. Luis Collado presento la charla titulada “Resistencia antibiótica en cepas de Campylobacter spp. aisladas de alimentos de origen animal en Chile” en el II SIMPOSIO INTERNACIONAL “AVANCES E INNOVACIÓN EN EL SECTOR AGROALIMENTARIO: EN TIEMPO DE PANDEMIA” organizado por Universidad Nacional Autónoma de Chota, Perú.

Septiembre 2021. Luis Collado presento la charla titulada “Campylobacter MDR” en el Curso de Microbiología Clínica de Curicó y Curso Universitario de Resistencia Bacteriana, CURB (CuriCurb 2021). Más información en https://www.curicurb.cl/


Agosto 2021. Mónica López-Cantillo presento el trabajo titulado “Campylobacter jejuni y otras campylobacterias emergentes en hígado vacuno, ¿una potencial vía de transmisión subestimada?” XXV Congreso Latinoamericano de Microbiología (ALAM 2021).


Diciembre 2020. Sofía Ochoa presento el trabajo titulado «Evaluación del potencial patogénico de especies entero-hepáticas del género Helicobacter aisladas de perros domésticos usando larvas de Galleria mellonela como modelo de infección» en el Congreso Digital de la Sociedad Chilena de Microbiología (SOMICh).

Junio 2020. Con la finalidad de realizar difusión y además como antecedentes para la formación continua de profesionales de la salud, hemos publicado un articulo sobre el actual escenario del diagnóstico y vigilancia epidemiológica de la campilobacteriosis en Chile en la Revista Chilena de Infectología.


SEPTIEMBRE 2019: Sofía Ochoa, Melina Cruzado y Luis Collado asistieron al 20th Campylobacter, Helicobacter and Related Microorganisms conference (CHRO 2019). Belfast, Irlanda del Norte.


NOVIEMBRE 2018: Sofía Ochoa ha presentado el trabajo titulado “Comparación de medios de cultivo y condiciones de crecimiento para el aislamiento de especies enterohepáticas de Helicobacter” en el XXIV Congreso Latinoamericano de Microbiología (ALAM 2018). Santiago, Chile.

OCTUBRE 2018: Luis Collado ha presentado la charla “Resistencia Antibiótica de Campylobacterias Patógenas Emergentes” en la Universidad Santo Tomás, Osorno, Chile.

AGOSTO 2018: Luis Collado ha presentado el trabajo titulado “Predominancia de los Complejos Clonales ST-21, ST-48 y ST-353 en cepas clínicas de Campylobacter jejuni resistentes a ciprofloxacino en Chile” en el Primer Curso Universitario de Resistencia Bacteriana (CURB 2018). Santiago, Chile.

ABRIL 2018. Melina Cruzado (Estudiante del Programa de Doctorado en Ciencias y Tecnología de los Alimentos, Universidad de Sao Paulo, Piracicaba, Brasil) ha terminado un periodo de investigación en nuestro laboratorio sobre la caracterización molecular de Arcobacter aislados de leche cruda y Queso Minas Frescal de Brasil. Te deseamos éxito en lo que queda del doctorado….un abrazo! En la foto de izda. a dcha: Sebastián Ruiz, Sofía Ochoa, Boris Vidal, y Melina Cruzado.


NOVIEMBRE 2017. Sofía Ochoa, Estefanía Parra, Boris Vidal y Luis Collado han participado en el XXXIV Congreso Chileno de Infectología en Concepción. La presentación oral realizada por B. Vidal ha obtenido el Premio ASM al mejor trabajo en Microbiología. Felicitaciones a todos los coautores del estudio y en especial a Boris. Noticia UACh

SEPTIEMBRE 2017. Durante el segundo semestre del 2017, hemos recibido la visita en nuestro laboratorio de dos estudiantes extranjeras: Estefanía Parra B. de la Universidad Católica de Manizales (Colombia) y de Nicolle Ferraz de Arruda (Universidad de Sao Paulo, Brasil). Bienvenidas campylobacteriologas!… En la foto de izda. a dcha: Estefanía Parra, Luis Collado, Boris Vidal, Sofía Ochoa y Nicolle Ferraz.
AGOSTO 2017: Luis Collado ha presentado la charla «Campylobacter spp. resistente a las fluoroquinolonas – un patógeno prioritario para la OMS» en los Coloquios de la SOMICH en la Universidad de Concepción, Chile.

SEPTIEMBRE 2016: Nataly Muñoz ha presentado el trabajo titulado «Predominancia de los complejos clonales CC-21 y CC-48 en cepas clínicas de Campylobacter jejuni resistentes a ciprofloxacino aisladas en el sur de Chile» en el XXIII Congreso Latinoamericano de Microbiología (ALAM 2016). Rosario, Argentina.

JUNIO 2016: Alberto Cáceres ha presentado la charla «Campylobacter ornithocola sp. nov., un nuevo miembro del complejo Campylobacter lari aislado de muestras fecales de aves silvestres» en la XVI Reunión del Grupo Especializado en Taxonomía, Filogenia y Biodiversidad de la Sociedad Española de Microbiología, en Santiago de Compostela, España.

NOVIEMBRE 2015: Luis Collado ha presentado el trabajo titulado «Recognition of two genomovars within Arcobacter cryaerophilus after a polyphasic taxonomic re-evaluation». En el 18th International workshop on Campylobacter, Helicobacter and related organisms (CHRO 2015). Rotorua, Nueva Zelanda.

JUNIO 2015: Luis Collado ha presentado la charla «Descubrimiento y caracterización de nuevos patógenos bacterianos – ¡el fondo del iceberg!». En el Ciclo de Charlas de la Facultad de Ciencias. Universidad Austral de Chile. Valdivia, Chile.

Noviembre 2012. Luis Collado coordino el Simposio «Taxonomía y Biodiversidad Microbiana» en el XXXIV Congreso Chileno de Microbiología desarrollado en Valdivia-Chile, y donde participaron el Dr. Ramón Roselló-Mora (CSIC-UIB, España), la Dra. María José Figueras (Universitat Rovira i Virgili, España), el Dr. Eduardo Álvarez (Universidad de Chile) y el Dr. Milko Jorquera (Universidad de la Frontera).
2012. Se dictó el Curso “Taxonomía Polifásica Aplicada al Diagnóstico Bacteriológico” . Además de sus organizadores, Dr. Luis Collado y Dr. Heriberto Fernández del Instituto de Microbiología Clínica de la U. Austral, contó con los invitados Dra. María José Figueras (Universitat Rovira i Virgili, España), quien asistió gracias a fondos otorgados por la American Society for Microbiology (ASM); y de la Universidad Austral de Chile Dr. Miguel Salgado, Mg. Cs. Mario González, Mg. Cs. María Paz Villanueva y Mg. Cs. Gustavo Medina. Más información en Noticias UACh.



